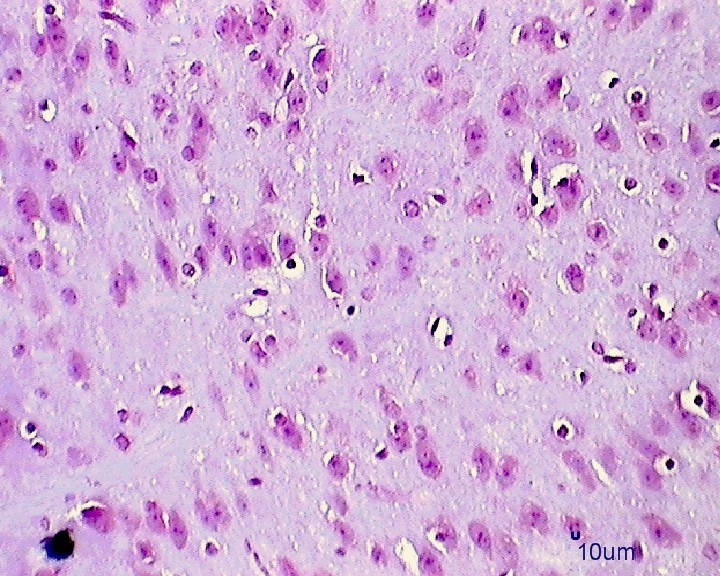

Int J Pharm Pharm Sci, Vol 7, Issue 6, 97-101Original Article
TELMISARTAN ALLEVIATES NITROSATIVE STRESS IN TURN DOPAMINERGIC DEGENERATION IN MICE MPTP MODEL OF PARKINSONISM–BIOCHEMICAL AND HISTOPATHOLOGICAL EVIDENCES
SEKAR SATHIYA1,2, CHIDAMBARAM SARAVANA BABU1,*
1Centre for Toxicology and Developmental Research (CEFT), Sri Ramachandra University, Chennai 600116, TN, India, 2Department of Biotechnology, Dr. M. G. R. Educational and Research Institute University, Chennai 600095, TN, India
Email: ceftpublications@gmail.com
Received: 20 Mar 2015 Revised and Accepted: 15 Apr 2015
ABSTRACT
Objective: Telmisartan (TEL), an angiotensin type 1 receptor blocker, exerts neuroprotection in MPTP induced Parkinson’s disease. The present study was aimed to investigate its effects on oxidative stress markers–inducible nitric oxide synthase (iNOS), nitric oxide (NO) and reduced glutathione (GSH) content in C57BL/6J mice brain.
Methods: Young healthy male C57BL/6J mice were injected intraperitoneally with MPTP at 80 mg/kg in two divided doses (2 x 40 mg/kg at 16h interval). TEL was administered one hour prior to first MPTP intoxication and thereafter once in two consecutive days. The animals were sacrificed 48 h after first MPTP injection and brains were collected for further analysis.
Results: TEL administration increased GSH content and decreased iNOS expression and NO level in MPTP intoxicated mice brains. Histopathological evaluation revealed that TEL decreased the cytoplasmic vacuolation and nuclear pigmentation in striatal and substantial nigral regions of MPTP intoxicated mice brain. The neuroprotective effect of TEL was further evidenced with increased neuronal nuclei (NeuN) immune fluorescence in MPTP mice brains.
Conclusion: The present study showed that TEL exerts neuroprotection by suppressing nitric oxide induced oxidative stress and the dopaminergic degeneration. The above finding suggests that TEL may act as a potential target in the management of PD.
Keywords: MPTP, Telmisartan, Oxidative stress, Dopaminergic degeneration.
INTRODUCTION
Oxidative stress and neuroinflammation are the two major hallmarks in various neurodegenerative disorders including Parkinson’s disease (PD). Increased inducible nitric oxide synthase (iNOS) expression and nitric oxide (NO) levels were observed in PD postmortem brains [1]. The involvement of NO in the pathogenesis of PD was also demonstrated in experimental animal models [2]. In addition, studies have shown that increased iNOS expressions and NO levels in striatal (ST) or substantia nigral (SNPc) regions following MPTP administration in C57BL/6J mice [3-6].
iNOS, induced by pro-inflammatory cytokines (TNF-α, IL-1β, and IFN-γ) produces highly toxic molecules such as NO [7-9] and reactive oxygen species (ROS) [10]. Under pathological conditions, NO contributes to overproduction of highly toxic intermediates such as peroxynitrite, nitrogen dioxide, carbonate and hydroxyl radicals [11, 12].
Another major event of NO neurotoxicity is through s-nitrosylation by modifying the cysteine residues, precursor for glutathione synthesis to nitrosothiols [13, 14]. Overproduction of NO ultimately results in loss of an electron transport chain by complex I inhibition, leading to mitochondrial dysfunction and intense ROS generation [15]. Decreased glutathione (GSH) level, most abundant antioxidant thiol residue involved in the detoxification of peroxides was observed in PD brain regions [16].
Increased production of ROS and decreased antioxidant capacity compromises essential cellular function. Increased attention has been paid recently in ameliorating PD through the renin angiotensin system (RAS) modulators. Previous studies confirmed that telmisartan (TEL), an angiotensin II type 1 receptor (AT1R) antagonist exerts neuroprotection in 1-methyl-4-phenyl-1,2,3,6-tetrahydropyridine (MPTP) mice model [17, 18]. The present study demonstrates the role of TEL on oxidative stress markers in MPTP intoxicated PD mice model.
MATERIALS AND METHODS
Chemicals and reagents
TEL was obtained as the gift from Sun Pharmaceutical Pvt. Ltd., Mumbai, India. MPTP and TRIzol reagent were purchased from Sigma Aldrich, USA. Mouse anti-neuronal nuclei (NeuN) and Tetramethylrhodamine (TRITC) conjugated goat anti-mouse IgG were obtained from Millipore, USA. PCR master cycler gradient was purchased from Genet Bio, Korea. 5-bromo-4-chloro-3-indolyl-phosphate/nitro blue tetrazolium (BCIP/NBT) substrate for alkaline phosphatase kit was obtained from Ge Nei™, Mumbai. Carboxy methyl cellulose (CMC) was obtained from Himedia, Mumbai. Unless mentioned, all other chemicals and reagents were of analytical grade.
Animal husbandry
Male C57BL/6J mice (18-22 g b. wt) obtained from the Central Animal facility, Sri Ramachandra University, Chennai was used for the study. Animals were housed in groups (5 animals/cage) in polypropylene cages in a well-ventilated room (air cycles: 12-15/h; recycle ratio: 70:30) under an ambient temperature of 22±3 °C and 40–65% relative humidity, with a 12-h light/dark artificial light cycle. They were provided with rodent feed (M/s. Provimi Animal Nutrition India Pvt. Ltd, India) and purified water ad libitum. Animals were acclimatized for 7 days to the laboratory conditions. Guidelines of “Guide for the Care and Use of Laboratory Animals” (Institute of Laboratory Animal Resources, National Academic Press 1996; NIH publication number #85-23, revised 1996) were strictly followed throughout the study. Institutional Animal Ethics Committee (IAEC), Sri Ramachandra University, Chennai, India approved the study (IAEC/XXII/SRU/159/2011).
Experimental design
Animals were divided into five groups with 10 in each group. Group I received vehicle (0.5% CMC), Group II received vehicle+MPTP, Group III and IV received TEL at 3 and 10 mg/kg, p. o, respectively [Two dose regimens were selected to investigate the dose dependent response]+MPTP, Group V received TEL at 10 mg/kg, p. o alone. MPTP was injected intraperitoneally at 80 mg/kg b. wt in two divided doses (2 x 40 mg/kg at 16 h apart). Vehicle or TEL was administered one hour before the first injection of MPTP and thereafter once a day for two consecutive days. Animals were euthanized using CO2 exposure and brain was collected for analysis, 48 hours after the first MPTP injection [19].
Reverse transcriptase–polymerase chain reaction (RT-PCR) analysis
RT-PCR was performed according to the manufacturer’s instructions using one step PCR kit method to determine the level of mRNA expression of iNOS. Briefly, total RNA was extracted from ST and SNpc brain regions using TRIzol Reagent (Sigma, USA).
After homogenization, the tubes were incubated for 10 min and centrifuged. Chloroform was added to the supernatant, allowed to incubate for 5 min at room temperature and centrifuged at 12000 rcf. Then, isopropyl alcohol was added to precipitate the total RNA and centrifuged for 15 min, following the incubation period of 10 min. The supernatant was decanted carefully; the pellet was washed three times with 75% ethanol, centrifuged and the pellet was allowed to air dry. The pellet was re suspended in RNase free water and stored in -80 °C until use. The isolated RNA was allowed to undergo reverse transcription and polymerization reaction to get cDNA using PCR master cycler gradient (Genet Bio, Korea). The gene expression was analyzed using the bands formed in agarose gel electrophoresis, captured using Gel documentation unit (Vilber Laumar, Germany) and quantified by Bio ID software.
Primers sequence used were as follows, β-actin: sense, 5’-CCT CTA TGC CAA CAC AGT GC-3’; antisense, 5’-GTA CTC CTG CTT GCT GAT CC-3’ and iNOS: sense, 5’-GTG TTC CAC CAG GAG ATG TTG-3’; antisense 5’-CTC CTG CCC ACT GAG TTC GTC-3’.
Reduced glutathione (GSH) content
GSH was estimated in brain SNpc and ST regions according to the method of Moren et al. [20]. 0.25 ml of 10% tissue homogenate was mixed with the equal volume of ice cold 5% TCA. The precipitate was removed by centrifugation at 4000 rpm for 10 min. To 0.1 ml supernatant, 0.25 ml of 0.2 M phosphate buffer (pH 8.0) and 0.5 ml of 5,5'-dithiobis-(2-nitrobenzoic acid) were added and mixed well. The intensity of colour developed was measured at 412 nm using UV spectrophotometer (Thermo Fisher Scientific, USA). The values were expressed in µM/mg protein.
Total protein
Total protein in SNpc and ST brain regions was estimated using Bradford reagent [21].
Nitrite levels
Nitric oxide (NO), which interacts with oxygen to produce nitrite, was estimated using Griess reagent [22]. 0.2 ml of 10% tissue homogenate was mixed with 1.8 ml of saline and 0.4 ml of 5-sulfosalicylic acid for protein precipitation. The precipitate was removed by centrifugation at 4000 rpm for 10 min. To 1 ml of supernatant, 2 ml griess reagent was added and mixed well.
The mixture was allowed to stand for 20 min under dark condition and the intensity of chromogen was read at 540 nm using UV spectrophotometer (Thermo Fisher Scientific, USA). The values were expressed in mM/mg tissue.
Histopathology
5 µM-thick paraffin sections through matched coronal levels of the SNpc and ST were stained with cresyl violet for histopathological evaluation and scoring [23] under light microscopy at x400 magnification (Motic DMB1–2MP, China). The number of nissl positive cells in the striatum and substantia nigra were counted with image analysis software (Motic DMB1–2MP, China). Percentage nissl positive cells were calculated as: (Number of positive cells/mm2)/ (Total number of cells/mm2) X 100.
Immunoflourescence
5 µM-thick paraffin sections through matched coronal levels of the SNpc and ST were processed as described above and non-specific binding was blocked by 1 h incubation in 1.5% BSA. Sections were incubated with primary antibody, mouse anti-NeuN (1:100) for one hour and then subsequently incubated with secondary antibody, TRITC conjugated goat anti-mouse IgG (1:20) for half an hour at room temperature. The number of positive cells in SNpc and ST was counted under x400 magnification with image analysis software (Motic DMB1–2MP, China). Percentage immunopositive cells were calculated as: (Number of immunopositive cells/mm2)/(Total number of cells/mm2) X 100.
Data analysis
Data were expressed as mean±Standard error of the mean (SEM). Mean differences between groups were analysed by one way ANOVA followed by Tukey’s multiple comparison as posthoc test using Graphpad Prism 5.0 (San Diego, USA) software. p value ≤ 0.05 was considered significant.
RESULTS
TEL down-regulated iNOS expression in MPTP intoxicated mice brain
SNpc and ST regions of MPTP mice brain showed a significant up-regulation of iNOS expression [F (4,10) = 112.2, p<0.01 and F (4,10) = 73.47, p<0.01, respectively] when compared to the vehicle treated mice. TEL (3 and 10 mg/kg) significantly ameliorated these changes (p<0.01) in both the regions (fig. 1).

Fig. 1: Effect of TEL on iNOS mRNA expression in MPTP intoxicated mice brain. Values were expressed in mean±SEM, n=3 animals/group, statistical analysis was performed using one way ANOVA followed by Tukey’s multiple comparison test, ## indicates p value<0.01 Vs group I, ** indicates p value<0.01 Vs group II
TEL decreased NO levels and increased GSH content in MPTP intoxicated mice brain
A significant increase in NO levels [F (4,10) = 97.15, p<0.01 and F (4,10) = 22.27, p<0.01, respectively] and decrease in GSH content [F (4,10) = 34.96, p<0.01 and F (4,10) = 64.00, p<0.01, respectively] were observed in SNpc and ST regions of MPTP mice when compared to vehicle treated mice. Oral administration of TEL (3 and 10 mg/kg) significantly decreased NO levels (p<0.05 and 0.01; p<0.01, respectively) and increased GSH content (p<0.01; p<0.05 and 0.01, respectively) in SNpc and ST regions when compared to MPTP mice (fig. 2).
TEL increased the nissl staining in MPTP intoxicated mice brain
SNpc and ST regions of MPTP mice brain showed a significant decrease in % nissl positive cells [F (4,10) = 159.8, p<0.01 and F (4,10) = 92.68, p<0.01, respectively] when compared to the vehicle treated mice. TEL (3 and 10 mg/kg) significantly (p<0.01) increased % nissl positive cells in both the regions, as compared to MPTP intoxicated mice (fig. 3).


Fig. 2: Effect of TEL on nitrite and GSH levels in MPTP intoxicated mice brain. Values were expressed in mean±SEM, n=3 animals/group, statistical analysis was performed using one way ANOVA followed by Tukey’s multiple comparison test, ## indicates p value<0.01 Vs group I, *,** indicates p value<0.05 and 0.01, respectively Vs group II.
TEL increased NeuN expressions in MPTP intoxicated mice brain
SNpc and ST regions of MPTP mice brain showed a significant decrease in % NeuN immunopositive cells [F (4,10) = 274.1, p<0.01 and F (4,10) = 86.24, p<0.01, respectively] when compared to the vehicle treated mice. TEL (3 and 10 mg/kg) significantly (p<0.01) increased % NeuN immunopositive cells in both the regions in comparison to MPTP mice (fig. 4).
DISCUSSION
Since the discovery of RAS in brain, several studies focused on the role of RAS modulators in the management of PD [24]. In the present study, TEL decreased iNOS expression and NO levels and increased GSH content which could be the, or at least in part, for the increased neuronal survival in MPTP intoxicated mice brains. This shows that TEL might play a vital function in the management of PD through the regulation of nitrosative stress and inflammatory pathway.
Increased levels of inflammatory mediators such as tumor necrosis factor alpha (TNFα), interleukin (IL)-1β and iNOS, along with activated microglia and astrocytes were observed in PD brain [25, 26]. Activation of microglia and inflammatory cytokines in SNPc and ST regions was also reported in acute MPTP mice model of PD [27]. The present study demonstrated the decreased iNOS expression in TEL administration, which may be through the regulation of these inflammatory processes.
It has been revealed that increased NO release, produced by iNOS was observed along with the inflammatory mediators [28]. NO in turn involved in mitochondrial electron transport chain dysfunction resulting in the over production of ROS [29]. NO also easily binds with superoxide anion (O2•) as well and forms a strong oxidant, peroxynitrite (ONOO•) which ultimately involves in the nitration of proteins, mainly in tyrosine residues,
 |
 |
 |
 |
 |
| A1 | A2 | A3 | A4 | A5 |
 |
 |
|
 |
 |
| B1 | B2 | B3 | B4 | B5 |

Fig. 3: Effect of TEL on % nissl positive cells in MPTP intoxicated mice brain. Pictures represent nissl positive cells of (A) SNPc and (B) ST brain regions X 400 magnification. (1) Normal control, (2) MPTP induced mice brain, (3) TEL (3 mg/kg b. wt.) administered MPTP mice brain, (4) TEL (10 mg/kg b. wt.) administered MPTP mice brain and (5) TEL (10 mg/kg b. wt.) administered normal mice brain. (C) Values were expressed in mean±SEM, n=4 animals/group, statistical analysis was performed using one way ANOVA followed by Tukey’s multiple comparison test, ## indicates p value<0.01 Vs group I, ** indicates p value<0.01 Vs group II
lipid oxidation, DNA strand breaks and leading to nitosative stress induced cell death [30, 31]. On the other hand, Clementi et al. [32] showed that persistent inhibition of mitochondrial respiration by NO results in the depletion of GSH in SNPc and ST brain regions. In the current study, decreased NO and increased GSH levels in TEL administration may be through its anti-oxidant effect in MPTP intoxicated mice brain. In addition, TEL has the potency to improve NeuN expression and restores the neurons from nuclear pigmentation and cytoplasmic vacuolation in SNPc and ST brain regions of MPTP mice brain. These data demonstrates the apparent role of TEL, AT1R antagonist, in regulating the inflammatory and oxidative stress in PD.
 |
 |
 |
 |
 |
| A1 | A2 | A3 | A4 | A5 |
 |
 |
 |
 |
 |
| B1 | B2 | B3 | B4 | B5 |

Fig. 4: Effect of TEL on % NeuN immunopositive cells in MPTP intoxicated mice brain. Pictures represent NeuN immunopositive cells of (A) SNPc and (B) ST brain regions X 400 magnification. (1) Normal control, (2) MPTP induced mice brain, (3) TEL (3 mg/kg b. wt.) administered MPTP mice brain, (4) TEL (10 mg/kg b. wt.) administered MPTP mice brain and (5) TEL (10 mg/kg b. wt.) administered normal mice brain. (C) Values were expressed in mean±SEM, n=4 animals/group, statistical analysis was performed using one way ANOVA followed by Tukey’s multiple comparison test, ## indicates p value<0.01 Vs group I, ** indicates p value<0.01 Vs group II
CONCLUSION
In conclusion, the present study reveals the neuroprotective effect of TEL against MPTP induced nitrosative stress and neurodegeneration in C57BL/6J mice. This study adds support to its restoring effect in acute conditions and it may be consider for clinical trials in PD.
CONFLICT OF INTERESTS
Authors declare no conflict of interest
ACKNOWLEDGEMENT
The authors thank the Science and Engineering Research Board (SERB), Department of Science & Technology, Govt. of India for funding the project. Authors also express their sincere thanks to Prof. Dr. S. Thanikachalam, Director–CEFT, SRU, for providing the facilities to carry out this project. Authors extend their thanks to all technical and non-technical staff of Centre for Toxicology and Developmental Research (CEFT), Sri Ramachandra University, Chennai, for their help during the conduct of the experiment.
Abbreviation
TEL–Telmisaratan; AT1R-Angiotensin type 1 receptor; MPTP-1-methyl-4-phenyl-1,2,3,6-tetrahydropyridine; PD-Parkinson’s disease; iNOS-Inducible nitric oxide synthase; NO-Nitric oxide; GSH-Reduced glutathione; SNPc-substantial nigra; ST–striatum; NeuN-Neuronal nuclei; ROS-Reactive oxygen species; RAS-Renin angiotensin system; CMC-Carboxy methyl cellulose; IAEC-Institutional Animal Ethics Committee; RT-PCR-Reverse Transcriptase–Polymerase chain reaction; SEM-Standard error of the mean.
REFERENCES
- Kavya R, Dikshit M. Role of nitric oxide/nitric oxide synthase in parkinson's disease. Ann Neurosci 2005;12:1-5.
- Singh S, Das T, Ravindran A, Chaturvedi RK, Shukla Y, Agarwal AK, et al. Involvement of nitric oxide in neurodegeneration: a study on the experimental models of Parkinson's disease. Redox Rep 2005;10:103-9.
- Chalimoniuk M, Lukacova N, Marsala J, Langfort J. Alterations of the expression and activity of midbrain nitric oxide synthase and soluble guanylyl cyclase in 1-methyl-4-phenyl-1,2,3,6-tetrahydropyridine-induced Parkinsonism in mice. Neurosci 2006;141:1033–46.
- Joniec I, Ciesielska A, Kurkowska-Jastrzebska I, Przybylkowski A, Czlonkowska A, Czlonkowski A. Age-and sex-differences in the nitric oxide synthase expression and dopamine concentration in the murine model of Parkinson’s disease induced by 1-methyl-4-phenyl-1,2,3,6-tetrahydropyridine. Brain Res 2009;1261:7–19.
- Liu J, Wang MW, Gu P, Ma QY, Wang YY, Geng Y, et al. Microglial activation and agerelated dopaminergic neurodegeneration in MPTP-treated SAMP8 mice. Brain Res 2010;1345:213–20.
- Ito T, Uchida K, Nakayama H. Neuronal or inducible nitric oxide synthase (NOS) expression level is not involved in the different susceptibility to nigro-striatal dopaminergic neurotoxicity induced by 1-methyl-4-phenyl-1,2,3,6-tetrahydropyridine (MPTP) between C57BL/6 and BALB/c mice. Exp Mol Pathol 2013;65:121–5.
- Bredt DS, Hwang PM, Snyder SH. Localization of nitric oxide synthase indicating a neural role for nitric oxide. Nature 1990;347:768-70.
- Barthwal MK, Srivastava N, Dikshit M. Role of nitric oxide in a progressive neurodegeneration model of Parkinson's disease in the rat. Redox Rep 2001;6:297-302.
- Heneka MT, Feinstein DL. Expression and function of inducible nitric oxide synthase in neurons. J Neuroimmunol 2001;114:8-18.
- Chen Y, Vartiainen NE, Ying W, Chan PH, Koistinaho J, Swanson RA. Astrocytes protect neurons from nitric oxide toxicity by a glutathione-dependent mechanism. J Neurochem 2001;77:1601-10.
- Szabo C, Ischiropoulos H, Radi R. Peroxynitrite: biochemistry, pathophysiology and development of therapeutics. Nat Rev Drug Discovery 2007;6:662–80.
- Reynolds MR, Berry RW, Binder LI. Nitration in neurodegeneration: deciphering the “Hows” “nYs”. Biochem 2007;46:7325–36.
- Hess DT, Matsumoto A, Kim SO, Marshall HE, Stamler JS. Protein Snitrosylation: purview and parameters. Nat Rev Mol Cell Biol 2005;6:150–66.
- Chung KK. Say NO to neurodegeneration: role of S-nitrosylation in neurodegenerative disorders. Neurosignals 2007;15:307–13.
- Bolanos JP, Peuchen S, Heales SJ, Land JM, Clark JB. Nitric oxide-mediated inhibition of the mitochondrial respiratory chain in cultured astrocytes. J Neurochem 1994;63:910-6.
- Dringen R, Gutterer JM, Hirrlinger J. Glutathione metabolism in brain. Eur J Biochem 2000;267:4912-6.
- Garrido-Gil P, Joglar B, Rodriguez-Perez AI, Guerra MJ, Labandeira-Garcia JL. Involvement of PPAR-gamma in the neuroprotective and anti-inflammatory effects of angiotensin type 1 receptor inhibition: effects of the receptor antagonist telmisartan and receptor deletion in a mouse MPTP model of Parkinson’s disease. J Neuroinflammation 2012;9:38.
- Sathiya S, Ranju V, Kalaivani P, Priya RJ, Sumathy H, Sunil AG, et al. Telmisartan attenuates MPTP induced dopaminergic degeneration and motor dysfunction through regulation of a-synuclein and neurotrophic factors (BDNF and GDNF) expression in C57BL/6J mice. Neuropharm 2013;73:98-110.
- Luchtman DW, Shao D, Song C. Behavior, neurotransmitters and inflammation in three regimens of the MPTP mouse model of Parkinson's disease. Physiol Behav 2009;98:130-8.
- Moren MS, Desplerra JW, Mannervik B. Levels of glutathione, glutathione reductase and glutathione S-transferase activities in rat lung and liver. Biochem Biophys Acta 1979;585:67-78.
- Bradford MM. A rapid and sensitive method for the quantitation of microgram quantities of protein utilizing the principle of protein-dye binding. Anal Biochem 1976;72:248-54.
- Green LC, Wagner DA, Glogowski J, Skipper PL, Wishnok JS, Tannenbaum SR. Analysis of nitrate, nitrite, and [15N] nitrate in biological fluids. Anal Biochem 1982;126:131-8.
- Bancroft JD, Gamble M. Theory and practice of histological techniques. 6th ed. London: Churchill Livingstone; 2008.
- Mertens B, Vanderheyden P, Michotte Y, Sarre S. The role of the central renin-angiotensin system in Parkinson’s disease. J Renin Angiotensin Aldosterone Syst 2010;11:49-56.
- Mogi M, Harada M, Riederer P, Narabayashi H, Fujita K, Nagatsu T. Tumor necrosis factor-alpha (TNF-alpha) increases both in the brain and in the cerebrospinal fluid from parkinsonian patients. Neurosci Lett 1994;165:208-10.
- Drouin-Ouellet J, Gibrat C, Bousquet M, Calon F, Kriz J, Cicchetti F. The role of the MYD88-dependent pathway in MPTP-induced brain dopaminergic degeneration. J Neuroinflammation 2011;8:137.
- Kurkowska-Jastrzebska I, Wronska A, Kohutnicka M, Czlonkowski A, Czlonkowska A. The inflammatory reaction following 1-methyl-4-phenyl-1, 2, 3, 6-tetrahydropyridine intoxication in mouse. Exp Neurol 1999;156:50-61.
- Di Filippo M, Chiasserini D, Tozzi A, Picconi B, Calabresi P. Mitochondria and the link between neuroinflammation and neurodegeneration. J Alzheimers Dis 2010;20:369–79.
- Bolanos JP, Peuchen S, Heales SJ, Land JM, Clark JB. Nitric oxide-mediated inhibition of the mitochondrial respiratory chain in cultured astrocytes. J Neurochem 1994;63:910-6.
- Singha S, Dikshit M. Apoptotic neuronal death in Parkinson’s disease: Involvement of nitric oxide. Brain Res Rev 2007;54:233–50.
- Tieu K, Ischiropoulos H, Przedborski S. Nitric oxide and reactive oxygen species in parkinson’s disease. IUBMB Life 2003;55:329–35.
- Clementi E, Brown GC, Feelisch M, Moncada S. Persistent inhibition of cell respiration by nitric oxide: crucial role of S-nitrosylation of mitochondrial complex I and protective action of glutathione. Proc Natl Acad Sci 1998;95:7631-7.